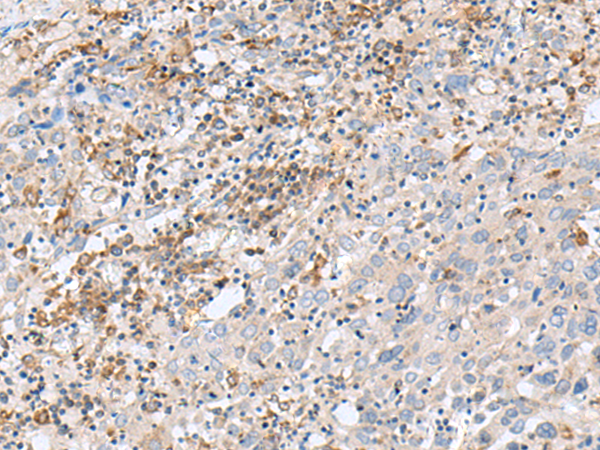

-
分类: 科研抗体货号: P06448别名: IL25; IL27; SF20; IL27w; C19orf10; R33729_1; EUROIMAGE1875335应用: WB,IHC反应种属: Human, Mouse
-
分类: 科研抗体货号: P06483别名: Cipp; INADL; hINADL; InaD-like应用: IHC反应种属: Human
-
分类: 科研抗体货号: P06458别名: UCP4应用: WB,IHC反应种属: Human, Mouse, Rat
-
分类: 科研抗体货号: P06447别名: IL-7应用: WB,IHC反应种属: Human, Mouse
-
分类: 科研抗体货号: P06482别名: GBAS应用: WB,IHC反应种属: Human, Mouse
-
分类: 科研抗体货号: P06457别名: ILRA; CD127; IL7RA; CDW127; IL-7R-alpha应用: WB,IHC反应种属: Human
-
分类: 科研抗体货号: P06446别名: DVS27; IL1F11; NF-HEV; NFEHEV; C9orf26应用: IHC反应种属: Human
-
分类: 科研抗体货号: P06481别名: Adrx; PAMM; FAM213A; C10orf58应用: WB反应种属: Human, Mouse, Rat
-
分类: 科研抗体货号: P06532别名: FNIPL; MAPO1应用: IHC反应种属: Human
-
分类: 科研抗体货号: P06479别名: GST3; LSST; GlcNAc6ST2; HECGLCNAC6ST应用: IHC反应种属: Human

鄂公网安备42018502007531号
鄂公网安备42018502007531号

